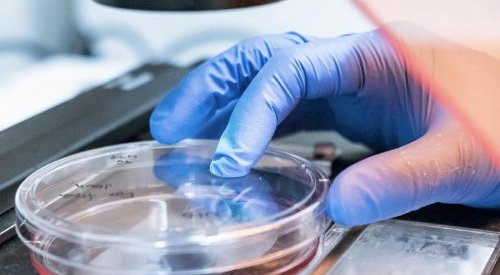

Science, R&D
Microbiome, fermentation: 2022 sheds a new light on bacteria!
They can be found absolutely everywhere in our lives. And we have learned to hate them, but recently started to change our view. Yet,...
Could turmeric be a key ingredient in future sun protection products?
Nature is full of riches whose benefits for skin and health have been exploited for thousands of years, but that doesn’t mean that all...
Study: Sulforafane may be helpful in the fight against hair loss
Broccoli and cauliflower continue to surprise us with unsuspected health benefits. Korean scientists have indicated that sulforaphane,...
BASF and Givaudan get OECD approval for first animal-free toxicology testing
The Organisation for Economic Co-operation and Development (OECD) has approved a new cruelty-free toxicology testing strategy jointly...
Artificial blue light has negligible impact on human skin, says Beiersdorf
The light emitted by the screens of our cell phones or laptops would not damage our skin, contrarily to recent public discourses....
“Clinical tests can also stimulate innovation in skin biology,” Dr Nico Forraz
The next edition of the Skin Science Days organised by Cosmet’in Lyon (formerly known as CED) will be held on May 20 and 21, 2021, with...
Study links frequent use of cosmetics to increased risk of endometriosis
A new study is questioning the possible presence of endocrine disruptors in certain cosmetics by establishing a correlation between an...
A model of 3D dermal microtissue to study the skin’s elastic properties
Gattefossé has joined forces with BioMeca, an expert in biomechanics and high resolution imaging in biology, to develop a model of 3D...
Octocrylene in sunscreen products degrades into benzophenone, study
Octocrylene, an organic UV filter frequently used in sunscreens and anti-aging creams, degrades into benzophenone, a compound suspected...
Silab tests its natural anti-acne active ingredient on a multifactorial model
The advanced research teams of Silab Softcare have developed a 3D in vitro model of reconstructed epidermis that mimics acneic skin....